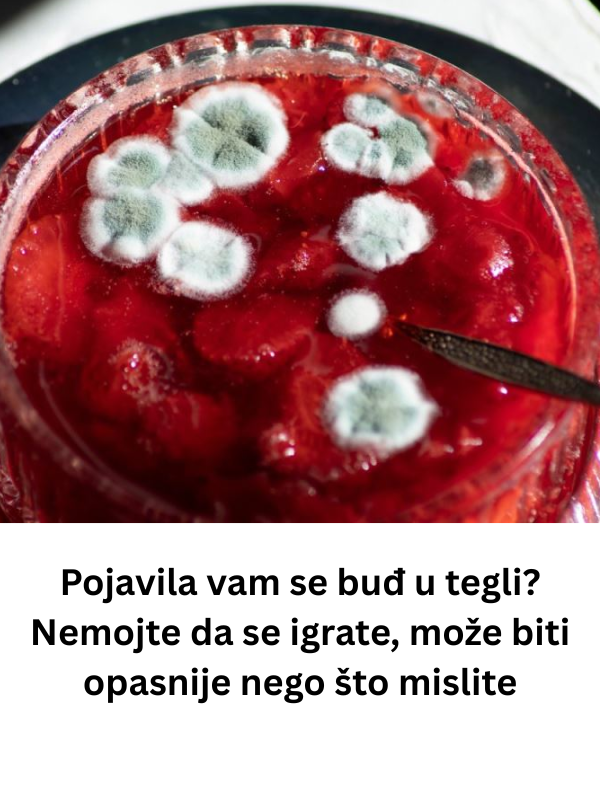

U današnjem članku govorićemo o problemu koji često muči domaćinstva prilikom čuvanja zimnice pojavi buđi u džemu. Na prvi pogled, možda izgleda bezazleno kada se na površini pojavi tanki sloj plesni, ali iza tog sloja kriju se mnogo ozbiljnije opasnosti.
- Mnogi imaju naviku da uklone samo površinski deo i nastave sa konzumiranjem, ne znajući da se time izlažu riziku po zdravlje. Razlog je jednostavan: plesan nije ograničena samo na ono što vidimo, već se njeni nevidljivi delovi šire celom teglom. Upravo zato je važno razumeti zašto se ne preporučuje korišćenje takvog džema i šta učiniti sa staklenkom kada se ovakva situacija dogodi.
Kada se na površini džema pojavi plesan, ona je samo vidljivi deo veće mreže koja se zove micelij. Ove sitne, korenaste niti prodiru kroz ceo sadržaj tegle, a mi ih ne možemo uočiti golim okom. Zato čak i kada uklonite vidljivi deo, cela masa džema već je zahvaćena. Posebno zabrinjava činjenica da određene vrste plesni proizvode mikotoksine – otrovne supstance koje se ne mogu ni videti, ni osetiti mirisom ili ukusom. Oni se nalaze u celom džemu i njihova konzumacija može imati ozbiljne posledice po zdravlje.
Mikotoksini mogu izazvati različite probleme: od blagih tegoba poput mučnine, povraćanja ili bolova u stomaku, pa sve do hroničnih i opasnih stanja kao što su oštećenja jetre i bubrega, pa čak i povećan rizik od razvoja karcinoma. Upravo zato stručnjaci ističu da nema bezbednog načina da se ovakav džem spase. Najvažnije pravilo glasi – kada se u tegli pojavi buđ, ceo sadržaj mora biti bačen, bez ikakvih pokušaja „spašavanja“.
Iako je sadržaj nepovratno uništen, sama staklena tegla ipak ne mora završiti u smeću. Staklo je materijal koji se može koristiti neograničen broj puta bez gubitka kvaliteta. Jedino što treba učiniti jeste da se tegla, zajedno sa poklopcem, temeljno opere vrućom vodom i deterdžentom. Nakon toga sledi obavezna sterilizacija – proces kojim se uništavaju sve preostale spore plesni i bakterije. Tek tada tegla može ponovo biti sigurna za korišćenje i spremna za novu turu zimnice.

- Kako bi se izbeglo ponavljanje ovakvih situacija, najbolji način jeste fokus na prevenciju. Postoji nekoliko ključnih koraka koji značajno smanjuju rizik od pojave buđi u džemu. Prvi i najvažniji je sterilizacija staklenki i poklopaca pre nego što se džem sipa. Najsigurnija metoda podrazumeva kuvanje u ključaloj vodi najmanje deset minuta. To je postupak koji nikako ne bi trebalo preskočiti, jer upravo on stvara osnovu za dugotrajnu ispravnost zimnice.
Sledeći korak je pravilno i hermetičko zatvaranje. Kada se džem sipa u teglu i ohladi, treba obavezno proveriti poklopac. Ako se prilikom pritiska čuje karakteristično „klik“, znači da tegla nije dobro zatvorena. Takav džem treba potrošiti prvi i čuvati ga u frižideru. Samo dobro zatvorena tegla stvara vakuum koji onemogućava ulazak vazduha i mikroorganizama.
Treći ključni element jeste pravilno skladištenje. Neotvorene tegle najbolje je čuvati na tamnom, suvom i hladnom mestu, daleko od izvora toplote i sunčeve svetlosti. Promene temperature mogu oslabiti vakuum i otvoriti put mikroorganizmima. Kada se tegla jednom otvori, džem obavezno treba držati u frižideru i trošiti ga u razumnom roku.
Na ovaj način može se produžiti trajnost zimnice, ali i sačuvati zdravlje ukućana. Vredi napomenuti da čak i najmanja količina buđavog džema može biti štetna, jer je nemoguće proceniti prisustvo mikotoksina bez laboratorijskih analiza. Upravo zato stručnjaci naglašavaju da je oprez jedini ispravan pristup.
- Dakle, osnovna poruka je jasna: ne uklanjajte samo površinu buđi i ne pokušavajte da spasete džem u kojem se već razvila plesan. Zdravlje je daleko vrednije od nekoliko kašika voćnog namaza. Umesto toga, bacite sadržaj, sačuvajte i pravilno sterilišite staklenku, a zatim se posvetite preventivnim merama za sledeću pripremu zimnice.

Na taj način dobićete sigurnu i ukusnu zimnicu, a iskustvo sa buđavim džemom poslužiće kao dragocena lekcija za budućnost. Čuvanje hrane nije samo stvar tradicije i navike, već i brige o zdravlju onih kojima je namenjena. Ako se pridržavate pravila sterilizacije, hermetičkog zatvaranja i pravilnog skladištenja, rizik od pojave plesni biće minimalan, a vaša zimnica ostaće ukusna i bezbedna tokom cele godine.












